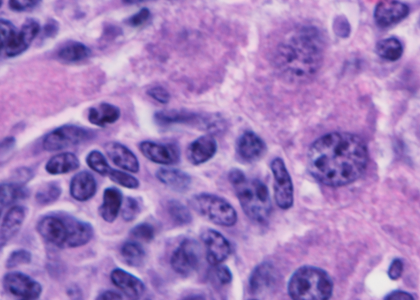

Shared Resources
It is our privilege and responsibility to share these resources, when possible, with the greater research community. Wistar Shared Resources, also known as core facilities, are available to Wistar investigators, affiliates, and outside researchers. Visit the individual core websites below or browse our online brochure to explore the opportunities Wistar provides for your research.
Many of the Shared Resources are supported by a Cancer Center Support Grant (CCSG) awarded by the National Cancer Institute (NCI) to the Ellen and Ronald Caplan Cancer Center.
Core Facilities
The Animal Facility Shared Resource facilitates research through humane and efficient management of animal populations.
The Bioinformatics Shared Resource continuously develops new and efficient approaches to data analysis as a response to emerging research needs.
The Biomedical Research Support Core (BRSC) provides a robust infrastructure to support mechanistic, patient-oriented research.
The Flow Cytometry Shared Resource provides investigators with the technological resources and professional assistance for high quality, multiparameter flow cytometry analyses and sorting.
The Genomics Shared Resource serves as a hub for consultation and scientific interaction relating to nucleic acid-based methods.
The Histotechnology Shared Resource provides services for fixing, processing and paraffin or OCT-embedding of all types of tissues for light microscopy (e.g. routine stains, immunohistochemistry or in situ hybridization).
The Humanized Models of Disease (HMD) Core provides investigators humanized mouse models to effectively conduct translatable research in biomedicine.
The imaging of complex cellular structures is used to determine how the temporal and spatial organization of regulatory events within cells, tissues and organisms impacts both normal and pathological processes.
The Molecular Screening and Protein Expression Shared Resource fosters collaboration by providing expertise in biochemical and cell-based assay development for high-throughput screening and compound profiling.
The Proteomics and Metabolomics Shared Resource provides high sensitivity proteomics and metabolomics analyses using state-of-the-art mass spectrometry instruments and methods.
Rigor and Reproducibility
National Institutes of Health (NIH) has set standards for grant applications to address reports of failure to replicate important basic/preclinical studies. See how Wistar complies with this policy.